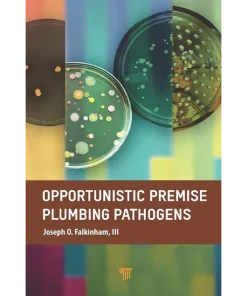
Opportunistic Premise Plumbing Pathogens

Shop
Showing 5050–5058 of 26071 results
Filter by price
Product categories
- Aerospace Books (225)
- Biomechanics Books (49)
- Biometrics Books (15)
- Biophysics Books (32)
- Biopolymer Books (67)
- Biostatistics Books (61)
- Biotechnology Books (373)
- Cellular and Molecular Biology Books (204)
- Clinical Science (6614)
- Hydrology and Limnology Books (102)
- Hygiene and Health Books (758)
- Immunology Books (238)
- Infectious Disease Books (70)
- Internal Medicine Books (130)
- Laboratory Sciences Books (112)
- Marine Biology and Oceanography Books (99)
- Medical Documents books (9)
- Medical Education Books (544)
- Medical Informatics Books (39)
- Metabolics Books (19)
- MRCOG Books (39)
- Nuclear Medicine books (29)
- Nutrition Books (123)
- Oncology Books (269)
- Others Health Sciences and Medicine Books (521)
- Others Life Sciences and Biology Books (285)
- Oxford Books (37)
- Paleontology Books (16)
- Parasitology Books (17)
- Parkinson Books (4)
- Plant Biology Books (109)
- Proteomics Books (19)
- Scrub (35)
- Soil Science Books (40)
- Sports Medicine Books (188)
- Stem Cells Books (46)
- Telemedicine and Health Books (27)
- Toxicology Books (68)
- Traditional Medicine Books (78)
- Tropical Medicine Books (3)
- Virology Books (43)
Showing 16831–16860 of 26071 results
-

Ophthalmic Ultrasonography and Ultrasound Biomicroscopy A Clinical Guide
Call for Price Quick View Compare -

Ophthalmic Ultrasound A Diagnostic Atlas 2nd Edition
Call for Price Quick View Compare -
Sale!

Ophthalmology
د.إ789.00Original price was: د.إ789.00.د.إ566.00Current price is: د.إ566.00. Quick View Compare -

Ophthalmology 3rd Edition
Call for Price Quick View Compare -

Ophthalmology 4th Edition
Call for Price Quick View Compare -

Ophthalmology 5th Edition
Call for Price Quick View Compare -

Ophthalmology 6th Edition By Myron Yanoff
Call for Price Quick View Compare -

Ophthalmology A Pocket Textbook Atlas 2nd Ed
Call for Price Quick View Compare -

Ophthalmology An Illustrated Colour Text 4th Edition
Call for Price Quick View Compare -

Ophthalmology At A Glance 2nd Ed
Call for Price Quick View Compare -

Ophthalmology Clinical Vignettes Oral Exam Study Guide II
Call for Price Quick View Compare -

Ophthalmology Examination Guide
Call for Price Quick View Compare -

Ophthalmology Fact Fixer
Call for Price Quick View Compare -
Sale!

Ophthalmology in Military and Civilian Casualty Care
د.إ661.00Original price was: د.إ661.00.د.إ567.00Current price is: د.إ567.00. Quick View Compare -

Ophthalmology Made Easy Post Graduate
Call for Price Quick View Compare -

Ophthalmology Made Ridiculously Simple 5th Edition
Call for Price Quick View Compare -

Ophthalmology Oral Board Review
Call for Price Quick View Compare -

Ophthalmology Q&A Board Review
Call for Price Quick View Compare -

Ophthalmology Review 3rd Edition
Call for Price Quick View Compare -

Ophthalmology Review A Case Study Approach 2nd Edition
Call for Price Quick View Compare -

Ophthalmology Review Manual 2nd Edition
Call for Price Quick View Compare -

Ophthalmology Secrets 5th Edition
Call for Price Quick View Compare -

Ophthalmology Secrets in Color 4th Edition
Call for Price Quick View Compare -

Ophthalmology Solved Question Papers 4th Edition
Call for Price Quick View Compare -

Opies Cardiovascular Drugs A Companion to Braunwalds Heart Disease 9th Ed
Call for Price Quick View Compare -

Opioid Dependence A Clinical and Epidemiologic Approach
د.إ802.00 Quick View Compare -
Sale!

Opioid Receptors
د.إ1,175.00Original price was: د.إ1,175.00.د.إ654.00Current price is: د.إ654.00. Quick View Compare -

Opioid Therapy in Infants Children and Adolescents
د.إ293.00 Quick View Compare -
Opportunistic Premise Plumbing Pathogens
د.إ787.00 Quick View Compare -

Opsin-free Optogenetics Technology and Applications
د.إ522.00 Quick View Compare
Recently Viewed Products
No recently viewed products to display

